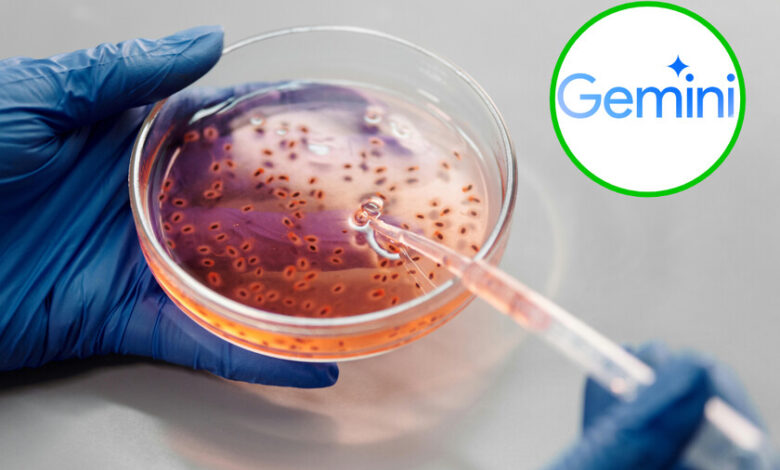

Estos científicos tardaron 10 años en resolver un problema con las superbacterias, mientras la IA de Google hizo lo mismo en 48 horas
Si algo es claro, es que cada día las inteligencias artificiales son más potentes. Tal es el caso de la variante científica de la IA de Google, Gemini, que logró resolver en apenas 48 horas un problema que había tomado casi 10 años a los científicos responder.
La investigación fue realizada por un equipo liderado por el profesor José R. Penadés, del Imperial College de Londres, quien estudiaba la resistencia de las superbacterias a los antibióticos, y que contactó con la BBC para su difusión.
Lo interesante es que el profesor decidió utilizar un «cocientífico«, que en realidad era una herramienta creada por Google. A partir de una breve instrucción, esta IA analizó el problema central de la investigación y llegó exactamente a la misma conclusión que el equipo científico en solo 48 horas.
El investigador indicó a la BBC que quedó sorprendido al descubrir este resultado, ya que su trabajo aún no había sido publicado y, por tanto, la IA no podía haberlo encontrado en el dominio público. Ante esta situación, Penadés contactó a Google para preguntar si la IA tenía acceso a su computadora, algo que la compañía negó.

Según Penadés, si hubieran contado desde el inicio con la hipótesis planteada por la IA de Google, habrían ahorrado años de trabajo, que incluyeron tanto el desarrollo teórico como la realización de experimentos para comprobar su investigación.
Además de coincidir con los investigadores, el profesor señaló que esta herramienta brindó otras sorpresas. No solo confirmó la hipótesis principal, sino que también presentó cuatro sugerencias adicionales, todas válidas, que el equipo nunca había considerado, y que ya habian comenzado a estudiar.
Los investigadores a cargo de este estudio analizaban cómo se crean algunas superbacterias, y partían de la hipótesis de que pueden formar una cola a partir de diferentes virus, lo que les permite propagarse entre especies.


Sus ideas eran exclusivas del equipo de investigación, no se habían publicado en ningún otro lugar ni compartido con terceros. A pesar de ello, la IA presentó un resultado similar al descrito en sus estudios.
El potencial uso de la IA en la investigación
Por lo pronto, Penadés es consciente de los temores que genera el uso de la IA y de la posibilidad de que pueda apropiarse del trabajo de los investigadores. Sin embargo, en el caso de la herramienta de Google, la considera más como «una herramienta extremadamente poderosa» con el potencial de transformar la ciencia.
Eso no es todo, pues el equipo de investigación también cree que la IA será útil en el futuro, ya que puede ayudarlos a encontrar más formas de combatir estas superbacterias, ya sea mediante el uso de antibióticos existentes o con el desarrollo de nuevas soluciones
DERECHOS DE AUTOR
Esta información pertenece a su autor original y fue recopilada del sitio https://www.xataka.com.mx/robotica-e-ia/estos-cientificos-tardaron-10-anos-resolver-problema-superbacterias-ia-google-hizo-48-horas




